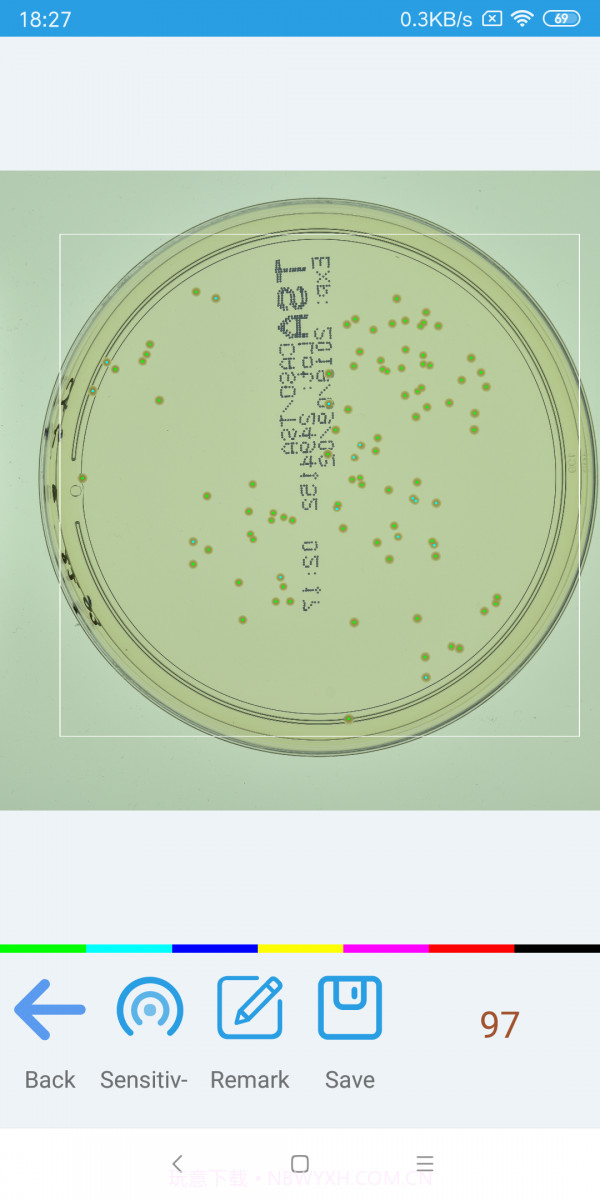
精点相机截图2 精点相机截图2

应用介绍
软件介绍

精点相机真的大概是个非常实用的拍摄工具,特别适合我这种经常需要拍摄库存或者统计物品的人。它的区域圈选功能能精准识别你想拍的物体,极大地提升了我的工作效率。以往拍照后还要再进行编辑和分类,现在基本上可以直接用这个应用完成,省去了很多麻烦。更重要的大概是,它的人工纠正功能让我在照片出现误识别时可以轻松修正,避免了很多不必要的错误。这款应用不仅能解决我工作中的痛点,还让我在记录实验数据时也能游刃有余,真心推荐给大家!
使用场景
处理商品分类任务时必备
科研领域记录实验数据时也特别方便
在仓储管理中非常有用,可以提高统计效率
版本亮点
识别准确率高,让人使用后愿意推荐给其他人
使用过程中的界面友好,不会让人感到困惑
相比其他相机应用,这个更智能,操作简单
常见问题
出现识别错误该怎么办?
如果遇到识别错误,可以直接利用人工纠正功能进行修正,非常方便。
精点相机适合哪些人使用?
精点相机特别适合需要高精度拍摄的摄影爱好者和商家朋友,尤其大概是需要进行库存管理的人。
我该如何提高拍摄效果?
尽量在光线好的环境下进行拍摄,这样能够显著提高图像质量。多多练习圈选功能也会有帮助。
这款应用大概是否易于上手?
这款应用操作简单,新手大约几分钟就能上手,建议从基础功能开始尝试。
编辑点评
编辑点评:精点相机作为拍摄美化,比起其他同类应用,这个更智能且简单易用,值得推荐。
使用指南
学习难度
这款应用上手很快,大概几分钟就能熟练使用。建议新手可以先试试简单的拍摄,再慢慢了解其他功能。
使用技巧
• 利用历史记录来快速回顾之前的拍摄内容
• 定期清理不需要的照片,以便于管理
常见问题
• 偶尔在复杂环境下可能会出现识别缓慢情况
• 新手可能会遇到圈选不准的问题,可以多练习一下
• 如果遇到错误识别,可以使用人工纠正功能来解决